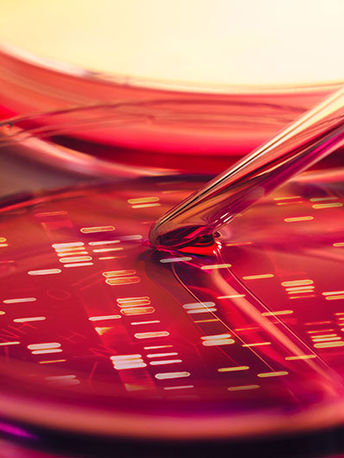

top of page

Quality Products and Exceptional Service
At Poincy Trading, we take pride in offering the finest commodity trading experience. Our commitment to quality and excellence sets us apart in the industry.

Trusted by
Industry Professionals
bottom of page